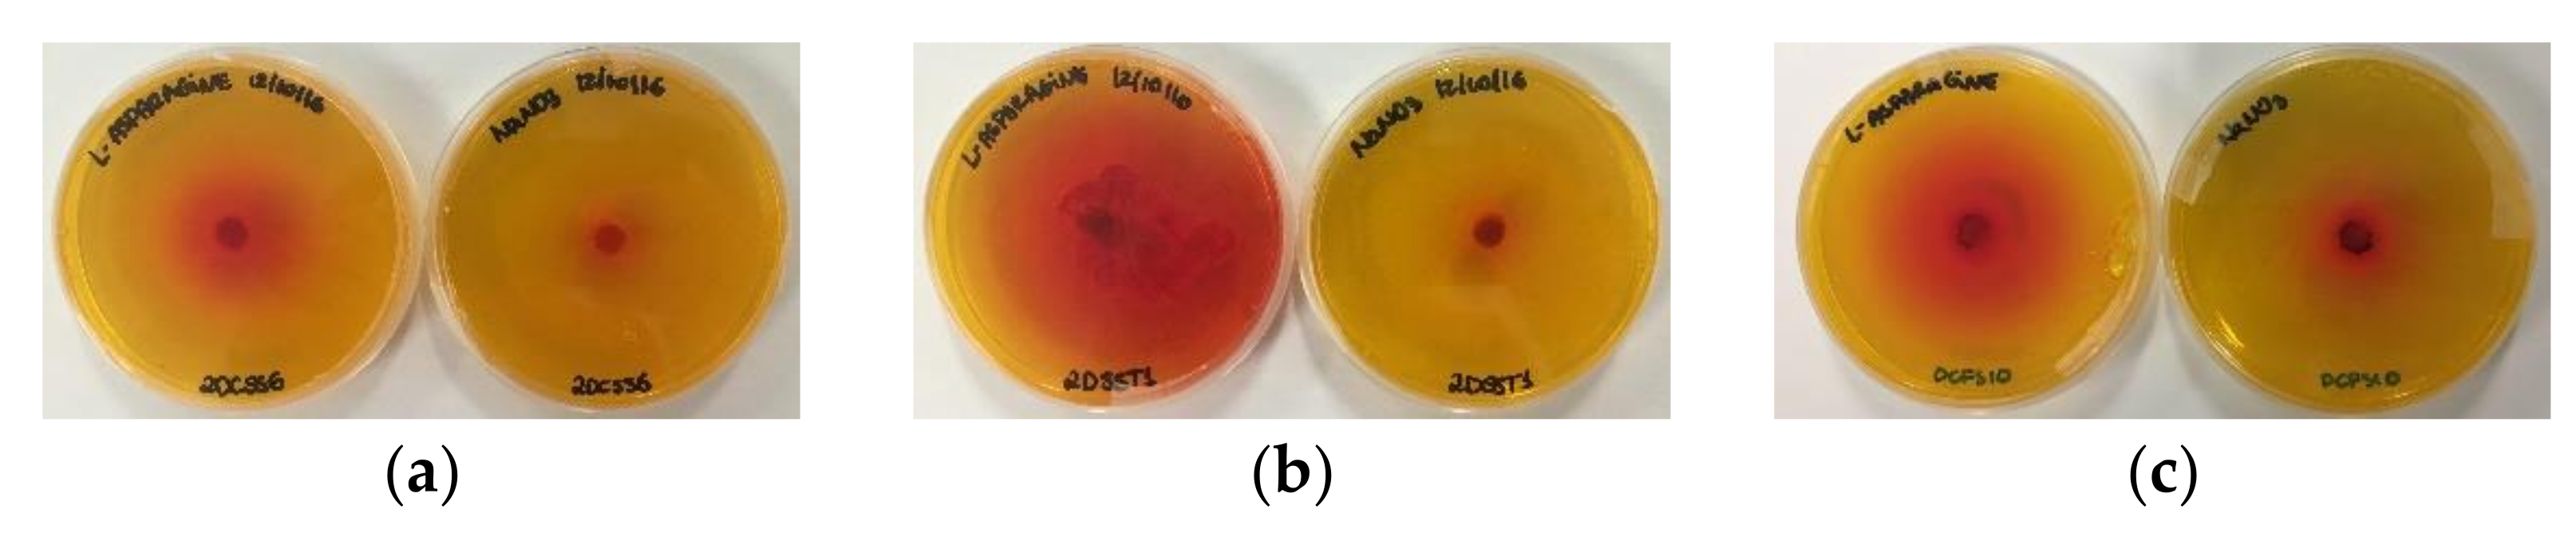
Pharmaceutics 13 01268 g001

Abstract
l-asparaginase is an enzyme used as treatment for acute lymphoblastic leukemia (ALL) due to its ability to hydrolyze l-asparagine, an essential amino acid synthesized by normal cells unlike neoplastic cells. The adverse effects of l-asparaginase formulations are associated with its glutaminase activity and bacterial origin; therefore, it is important to find new sources of l-asparaginase-producing eukaryotic microorganisms with low glutaminase activity. This work evaluated the biotechnological potential of filamentous fungi isolated from Brazilian Savanna soil and plants for l-asparaginase production. Thirty-nine isolates were screened for enzyme production using the plate assay, followed by measuring enzymatic activity in cells after submerged fermentation. The variables influencing l-asparaginase production were evaluated using Plackett–Burman design. Cell disruption methods were evaluated for l-asparaginase release. Penicillium sizovae 2DSST1 and Fusarium proliferatum DCFS10 showed the highest l-asparaginase activity levels and the lowest glutaminase activity levels. Penicillium sizovae l-asparaginase was repressed by carbon sources, whereas higher carbon concentrations enhanced l-asparaginase by F. proliferatum. Maximum enzyme productivity, specific enzyme yield and the biomass conversion factor in the enzyme increased after Plackett–Burman design. Freeze-grinding released 5-fold more l-asparaginase from cells than sonication. This study shows two species, which have not yet been reported, as sources of l-asparaginase with possible reduced immunogenicity for ALL therapy.
1. Introduction
The leading cause of death from disease among children is cancer, with leukemias being the most common type diagnosed in children up to 14 years of age, mainly acute lymphoblastic leukemia (ALL). l-asparaginase (EC 3.5.1.1; l-asparagine amidohydrolase), listed by the World Health Organization as an essential medicine, is an important enzyme in the pharmaceutical field that has been used for ALL treatment in children since 1970 [1,2]. Its anti-leukemic effect relies on the hydrolysis of l-asparagine, an amino acid required for the biosynthesis of proteins that neoplastic cells cannot synthesize due to lack of l-asparagine synthetase, unlike normal cells. l-asparaginase and asparagine synthetase can also use glutamine as substrate: l-asparaginase cleaves its amino group off at a slower rate and asparagine synthetase uses glutamine to provide the amine and connects to aspartate, thus forming asparagine [3,4]. Lang first reported l-asparaginase activity in 1904, followed by Furth and Friedmann in 1910 and Clementi in 1922 [5]. In 1953, Kidd described the regression of transplanted lymphomas induced in vivo in mouse and rat cells by guinea pig serum, which was later attributed to its l-asparaginase activity [6]. However, the need for large-scale production and purification of this enzyme for therapeutic work from guinea pigs was difficult, which led to a search for alternative sources with similar anti-leukemic effects. l-asparaginase is widely distributed in nature, being found in plants, microorganisms, and tissues of several animals such as fishes, mammals, and birds. Although enzyme properties and tumor inhibitory activity differ between organisms, microorganisms such as fungi and bacteria were found to be efficient and inexpensive sources of l-asparaginase due to large-scale production and their ability to grow easily on simple and inexpensive substrates [2,7,8].
l-asparaginase production is divided into upstream and downstream processing, where the upstream process development includes the selection of the cell line, culture media, selection of the cultivation process, bioreactor parameters such as pH and temperature, and optimization, while downstream processing includes all the steps required for enzyme purification [9]. Commercialized l-asparaginase formulations include native and PEGylated asparaginases from Escherichia coli and a native asparaginase purified from Erwinia carotovora [10]. However, adverse effects have been reported when E. coli asparaginase is administered, ranging from mild allergic reactions to anaphylactic shock in approximately 5–50% of the patients treated in various clinical trials [11]. Erwinia asparaginase, with similar antitumor activity but of different antigenic structure, is administered in responding but antigenically sensitive patients as an alternative to E. coli asparaginase [8]. However, allergic reactions in children with leukemia and lymphoma and venous thrombotic complications in adults undergoing induction treatment for ALL have been reported when native asparaginases from E. coli and Erwinia were administered [12,13]. Additionally, the formation of anti-Erwinia asparaginase antibodies and subsequently altered pharmacokinetics of Erwinia asparaginase during intravenous and intramuscular therapy were reported [14]. Although the biological half-life of asparaginase is extended through the PEGylation process, plasmatic asparagine and glutamine are hydrolyzed into ammonia, which may be responsible for the high incidence of symptomatic hyperammonemia in children with ALL receiving PEG-asparaginase [15]. An immune response, given partly by the protein’s large size and bacterial origin, is promoted by cleavage of l-asparaginase by normal and leukemic lymphoblasts through lysosomal proteases, thus potentiating antigen processing, which is the main reason for the interruption of l-asparaginase treatment [16]. In this scenario, an enzyme that leads to fewer side effects could be found in other microbial sources such as eukaryotic microorganisms, which present potentially better compatibility with the human immune system due to their evolutionary proximity [17,18]. Another factor that contributes to asparaginase-associated toxic side effects is its glutaminase activity [19]. Additionally, certain cells of the body may be sensitive to a deficiency of glutamine as an action of glutaminase [20]. Among the reported asparaginase formulations, there are asparaginases with undetected glutaminase activity, others with low to moderate activity, and some others with augmented glutaminase activities. Of the three asparaginases licensed by the US Food and Drug Administration, all of which are fermentation products, E. coli asparaginases have relatively low glutaminase activity, while Erwinia asparaginase has a higher glutaminase moiety, approximately 10-fold higher than that of E. coli and, therefore, KM and VMAX more favorable for deamination of glutamine [21].
In addition to its use as an antitumor drug, application of asparaginase in the food industry offers a possible alternative method for mitigating acrylamide that should have a limiting effect on the overall formation of Maillard products. Non-enzymatic browning generally occurs at temperatures above 100 °C and is responsible for the color and flavor development of fried and cooked foods. The predominant route for acrylamide formation, a carcinogen, is through the Maillard reaction between asparagine and reducing sugars. Asparaginase can reduce the level of free asparagine by specifically removing one of the essential acrylamide precursors [22]. Commercially, there are two preparations of asparaginase derived from fungi used by the food industry: PreventASe® is a recombinant form of the enzyme derived from Aspergillus niger and Acrylaway® is the trade name of a native asparaginase obtained from Aspergillus oryzae [23].
The Brazilian Savanna, also known as Cerrado, is a global biodiversity hotspot, with over 4800 plant and vertebrate species found nowhere else [24,25]. Located in the center of Brazil with outliers in São Paulo and the Northeast, the continuous Brazilian Savanna region is made up of a core area comprising almost all of Goiás, western Bahia, western Minas Gerais, and all of eastern Mato Grosso, with its geographical center near the city of Goiás Velho, west of Brasília. The Brazilian Savanna has tropical vegetation, with an average annual temperature of 20–26 °C. Extreme temperatures vary from 14 °C to 44 °C in southern São Paulo. The Cerrado climate is characterized by a rainy season followed by a dry season. The average rainfall per year ranges from 750 to 2000 mm (in São Paulo 1000–1500 mm), and the average rainfall of the driest month (July or August) during the dry season ranges from 5 to 40 mm with an average of 10–30 mm [26]. An appealing advancement in therapeutic applications with fewer side effects is to explore microorganisms isolated from extreme environments [27,28,29,30,31]. Therefore, we investigate whether filamentous fungi adapted to Brazilian Savanna climate conditions isolated from the soil and plants of the Goiás (GO) and Distrito Federal (DF) regions possess a potential biotechnological application in l-asparaginase production of pharmaceutical interest with low glutaminase activity, thus potentially less immunogenic, and optimize the upstream processing for enhanced l-asparaginase production of selected fungi.
2. Materials and Methods
2.1. Fungal Strains and Maintenance
Soil samples were collected in Brasília—DF and Goiás—GO, Brazil (Savanna region) in sterilized flasks containing 10 mL of sterile saline solution. The collected soil was subjected to serial dilution in sterile saline and an aliquot of each soil dilution was deposited onto potato dextrose agar (PDA) supplemented with 0.1% (w/v) ampicillin and incubated at 28 °C. The strains isolated from the Brazilian Savanna soil were deposited within the scope of the SisBiota Brasil (National System of Research in Biodiversity—CNPq) of filamentous fungi with authorization to access or send a sample of the genetic heritage component number 010770/2013-5 and access authorization by the National Genetic Heritage Management System and the Traditional Knowledge Associated Genetic Heritage Management Council in compliance with the provisions of Law No. 13,123/2015 and its regulations (registration number: AEFBB51 Pérola de Oliveira Magalhães Dias Batista). The strains are maintained by the Laboratory of Enzymology of the Institute of Biological Sciences at University of Brasília, Brazil, and were donated by Professor Edivaldo Ximenes Ferreira Filho.
Leaves of plants grown in the Brazilian Savanna were harvested in Darcy Ribeiro Campus of the University of Brasília, Brazil, and surroundings. The endophytic fungi were isolated [32] and grown on Sabouraud dextrose agar with chloramphenicol and 2% (w/v) malt extract and incubated at 28 °C. All soil and endophytic isolates were maintained by transfer of mycelial discs (agar plugs of 8 mm in diameter) onto fresh plates and incubated at 28 °C. Isolated A. terreus 2DCSS6 was used as a positive control in l-asparaginase screening assays [27].
2.2. Culture Media
Growth induction culture medium: 2.4% (w/v) potato dextrose broth and 1% (w/v) yeast extract
MCDM 1: 0.2% (w/v) glucose, 1.0% (w/v) l-asparagine, 0.152% (w/v) KH2PO4, 0.052% (w/v) KCl, 0.052% (w/v) MgSO4·7H2O, trace amounts of CuNO3·3H2O, ZnSO4·7H2O and FeSO4·7H2O and 2% (w/v) agar. The medium was supplemented with 0.009% (w/v) stock solution of 2.5% (w/v) phenol red prepared in ethanol and the final pH of the medium was adjusted to 6.2.
MCDM 2: 1.71% (w/v) l-proline, 1.99% (w/v) NaNO3, 1.38% (w/v) l-asparagine, 0.65% (w/v) glucose, 0.0152% (w/v) K2HPO4, 0.052% (w/v) MgSO4·7H2O, 0.052% (w/v) KCl, 0.001% (w/v) ZnSO4·7H2O, 0.001% (w/v) FeSO4·7H2O, 0.001% (w/v) CuSO4·5H2O, pH adjusted to 6.5 with 5 M KOH.
MCDM 3: growth induction medium supplemented with MCDM2.
MCDM 4: 0.152% (w/v) K2HPO4; 0.052% (w/v) KCl; 0.052% (w/v) MgSO4·7H2O; 0.001% (w/v) ZnSO4·7H2O; 0.001% (w/v) FeSO4·7H2O and 0.001% (w/v) CuSO4·5H2O.
2.3. Semi-Quantitative l-Asparaginase Screening
Semi-quantitative screening of l-asparaginase-producing microorganisms was carried out by solid-state method using modified Czapek Dox medium (MCDM) 1 [33]. Control plates were prepared as described above, replacing l-asparagine with sodium nitrate as nitrogen source. The media were autoclaved and poured into plates (20 mL). One mycelial disc of each isolate was inoculated onto l-asparaginase-screening and control plates and incubated at 28 °C for 48 h. The colony diameter and zone diameter were determined by measuring the inner and outer diameter of the microorganisms’ growth and enzyme production, respectively. Zone index was calculated as the ratio of outer to inner diameter as shown in Equation (1) [27].
2.4. Quantitative l-Asparaginase Screening
Quantitative screening of l-asparaginase-producing microorganisms was carried out by measuring enzyme activity in fungal cells. All submerged fermentation experiments were carried out in autoclaved 250 mL Erlenmeyer flasks containing 50 mL of culture medium, in duplicate. One mycelial disc of each isolate was inoculated into a growth induction culture medium incubated at 30 °C and 120 rpm for 72 h. The culture media were filtered, and the biomass was transferred to MCDM2 [34]. The flasks were incubated at 30 °C and 120 rpm for 120 h. The culture media were filtered, and the biomass was harvested.
2.5. Determination of l-Asparaginase Activity
Enzyme assay was performed by measuring the l-asparaginase activity in the cells from the amount of aspartate hydroxamate produced from asparagine and hydroxylamine [35]. The reaction mixture consists of 0.1 g fungal cells, 1.5 mL 50 mM Tris-HCl buffer pH 8.6, 0.2 mL 100 mM stock l-asparagine solution (final concentration 10 mM) and 0.2 mL 1 M stock hydroxylamine solution (final concentration 100 mM) previously neutralized with 2 M NaOH (total volume 2 mL). The reaction mixture was incubated at 37 °C and 200 rpm. After 30 min, 0.5 mL ferric chloride reagent (10% (w/v) FeCl3 and 20% (w/v) trichloroacetic acid in 0.66 M HCl) was added. Sample blank was performed with incubation of the buffer and the sample under the same conditions described above, followed by addition of l-asparagine and hydroxylamine stock solutions after ferric chloride reagent. The samples were centrifuged at 9000 rpm for 5 min at 4 °C. The absorbance of the supernatant was measured in a spectrophotometer at 500 nm. A l-aspartic acid β-hydroxamate standard curve (0–3.0 µmol) was constructed with 50 mM Tris-HCl buffer pH 8.6 and 0.5 mL ferric chloride reagent, in triplicate. The obtained equation was y = 0.3029x + 0.0017, R2 = 0.9998, where y is the absorbance and x is the l-aspartic acid β-hydroxamate formed in µmol. For all cell analyses, each isolate was evaluated with two biological repetitions performed in analytical duplicates (n = 4) and the results are presented as mean ± standard deviation of enzyme activity. One unit of l-asparaginase was defined as the amount of enzyme needed to form 1 µmol of l-aspartic acid β-hydroxamate per minute per gram of cell as shown in Equation (2).
2.6. Determination of l-Glutaminase Activity
The isolates that presented the largest l-asparaginase halos on the plate assay and the highest l-asparaginase activity values were further screened for glutaminase activity under submerged fermentation. One mycelial disc of selected isolates was inoculated into MCDM3 incubated at 30 °C and 120 rpm for 120 h. Glutaminase activity was quantified as described for l-asparaginase by replacing l-asparagine for glutamine as the reaction substrate. One unit of glutaminase was defined as the amount of enzyme needed to form 1 µmol of glutamic acid γ-hydroxamate per minute per gram of cells. Statistical significance was determined using unpaired t-test, with alpha = 0.05. Each fungal isolate was analyzed individually using GraphPad Prism software v.5.01 to evaluate significant differences between l-asparaginase and glutaminase activity levels.
2.7. Identification of the Fungal Species
2.7.1. DNA Extraction and PCR Amplification
Genomic DNA extraction was performed using Wizard Genomic DNA Purification Kit (Promega Corporation, Madison, WI, USA) from mycelia grown on PDA, incubated at 28 °C for 7 days. DNA concentration and quality were determined using Nanodrop ND-1000 spectrometer (Thermo Scientific, Waltham, MA, USA) and preparations were adjusted to 20 ng/µL of the DNA template.
Amplification reactions were performed with the primers for each gene using GoTaq® DNA Polymerase (Promega Corporation, Madison, WI, USA) according to the manufacturer’s instructions. The 3’ end of the 18rDNA, ITS1, 5.8S rDNA, ITS2 and the 5’ end of the 28rDNA (its) were amplified using the primer pair ITS1-F (5’-CTTGGTCATTTAGAGGAAGTAA-3’)/ITS-4 (5’-TCCTCCGCTTATTGATATGC-3’) [36,37]. PCR amplifications of β-tubulin (tub2), elongation factor-1 alpha (ef-1α), calmodulin (cam) and RNA polymerase II subunit (rpb2) were performed using the following primer pairs: Bt2a (5’-GGTAACCAAATCGGTGCTGCTTTC-3’)/Bt2b (5’-ACCCTCAGTGTAGTGACCCTTGGC-3’) [38]; EF1-728F (5’-CATCGAGAAGTTCGAGAAGG-3’)/EF1-986R (5’-TACTTGAAGGAACCCTTACC-3’) [39]; cmd5 (5′-CCGAGTACAAGGAGGCCTTC-3′)/cmd6 (5′-CCGATAGAGGTCATAACGTGG-3′) [40]; and fRPB2-5F (5′-GA(T/C)GA(T/C)(A/C)G(A/T)GATCA(T/C)TT(T/C)GG-3′)/fRPB2-7cR (5′-CCCAT(A/G)GCTTG(T/C)TT(A/G)CCCAT-3′) [41], respectively.
PCRs were performed using the recommended regions for each genus, i.e., tub2, ef-1α, and its for Fusarium [42,43] and tub2, cam, its and rpb2 for Penicillium [44]. PCR was performed with an initial denaturation of 95 °C for 4 min, followed by 35 cycles of 95 °C for 30 s (its and ef-1α) or 94 °C for 1 min (rpb2, tub2 and cam), annealing at 55 °C (its), 58 °C (ef-1α) for 30 s, 47 °C (rpb2), 58 °C (tub2) or 50 °C (cam) for 1 min, initial extension at 72 °C for 30 s (its) or 1 min and at 72 °C for 10 min on the final extension. PCR amplicons were analyzed by 1.0% agarose gel electrophoresis along with a DNA molecular weight marker (GeneRuler 1kb gene, Thermo Fisher Scientific, Waltham, MA, USA). The PCR products were purified using a Pure Link PCR purification kit (Thermo Scientific) and sequencing was performed directly from the purified PCR-amplified fragments using the automated sequencer MegaBACE 500™.
2.7.2. DNA Sequencing and Phylogenetic Analysis
The nucleotide sequence datasets were constructed using tub2 and ef-1α for Fusarium [42,43], or tub2, cam, its and rpb2 for Penicillium [44,45] from the two isolates characterized here, and representative isolates of the Fusarium or Penicillium. To test possible topological incongruences, phylogenetic trees were individually obtained from each genomic region. Multiple alignments were obtained with MAFFT v7. Finally, phylogenetic trees were reconstructed, for the concatenate data (its, cam, tub2, rpb2 for Penicillium or tub2 and ef-1α for Fusarium), using Bayesian inference (BI). The best substitution models for each partition were determined with MrModeltest [46]. The CIPRES web portal [47] was used to run MrBayes v3.2.1 [48]. The Markov chain Monte Carlo (MCMC) analysis was run with a total of 10 million generations, sampling every 1000 generations. The convergence of the log likelihoods was confirmed using TRACER v1.7.1 [49]. The first 25% of the sampled trees were discarded as burn-in, with the posterior probability (PP) values calculated with the remaining trees [50]. The phylogenetic tree was edited in FigTree v1.4 [49] and Inkscape (www.inkscape.org, accessed on 3 July 2020).
2.8. Screening of Nutrient and Culture Conditions by Plackett–Burman Design
Twelve independent variables previously evaluated in the optimization of the culture medium for the production of l-asparaginase by filamentous fungi [34,51,52] were selected to evaluate their effects on l-asparaginase activity and specific enzyme activity by Plackett–Burman design (PBD) at two levels (Table 1).
Table 1.
Values of the variables employed in Plackett–Burman experimental design.
The PBD matrix and the data analysis were determined using the software Protimiza Experimental Design with 16 combinations of the 12 variables to be evaluated of one genuine repetition each, with triplicates of the central point, totaling 19 runs. The isolates that presented the highest levels of l-asparaginase activity with the lowest values of glutaminase activity were inoculated into MCDM4 combined with variables according to the PBD matrix (Table 2), cultivated at 120 rpm for 48 h (Penicillium sp. 2DSST1) and 96 h (Fusarium sp. DCFS10).
Table 2.
Plackett–Burman experimental design matrix for the screening of variables for l-asparaginase activity (Y1) and specific enzyme activity (Y2) by P. sizovae and F. proliferatum.
The culture media were filtered, and the biomass was harvested, washed with distilled water, weighed, and stored at −80 °C. Enzyme extraction was carried out with frozen cells ground in a pre-chilled mortar and pestle in an ice bath until a powder was obtained. The macerated biomass was suspended (0.5 g mL−1) in 50 mM Tris-HCl buffer pH 8.6 and homogenized on a vortex for approximately one minute. The homogenate was centrifuged at 4000× g for 5 min at 4 °C and the supernatant was used as a crude enzyme extract. l-asparaginase activity assay was performed as described previously with a crude enzyme extract (0.1 mL) in place of cells. Therefore, one unit of l-asparaginase was defined as the amount of enzyme needed to form 1 µmol of l-aspartic acid β-hydroxamate per minute per mL of crude extract. All crude extract analyses were performed in triplicate within each biological repetition (n = 3) and the results are presented as mean of enzyme activities with standard deviation for each isolate.
2.9. Quantification of Total Protein
Protein quantitation of samples submitted to the microbial cell disruption method was determined with Pierce BCA Protein Assay Kit (Thermo Scientific, Waltham, MA, USA) to calculate the specific enzyme activity (U mg−1). In total, 200 µL of a freshly prepared reagent was added to a 25 µL aliquot of the supernatant of the disrupted cell sample, in triplicate, into a 96-well plate and incubated at 37 °C for 30 min. The absorbance of the reaction was measured on a spectrophotometer at 562 nm. A bovine serum albumin standard curve (0–2.0 mg mL−1) was constructed with 50 mM Tris-HCl buffer pH 8.6, in triplicate, to determine the total protein concentration in samples.
2.10. Kinetic Parameters of Cellular Growth and l-Asparaginase Activity
The kinetic parameters of cellular growth and l-asparaginase activity produced by the selected isolates were evaluated before and after the screening of culture media variables. A mycelial disc of the selected isolates was inoculated into MCDM3 as described previously and incubated at 30 °C and 120 rpm for 120 h. The selected isolates were cultivated in the culture medium in which the highest l-asparaginase activity value was obtained according to PBD, incubated at 32 °C and 120 rpm for 120 h. The cells were harvested every 24 h, weighed, the enzyme was extracted, and l-asparaginase activity was determined. The l-asparaginase specific activity was calculated and plotted until biomass started to decrease, indicating cell death. The maximum biomass productivity (PX,max), maximum enzyme productivity (PE,max), specific growth rate (µmax), specific enzyme productivity (μE,max) and biomass conversion factor in enzyme (YE/X) were calculated according to Equations (3)–(7), respectively, where X is the biomass concentration (g L−1), E is the enzymatic activity (U L−1) and t is the time (h).
2.11. Fungal Cell Disruption Mechanical Methods for l-Asparaginase Release
Freeze-grinding and sonication of fungal cells were compared to evaluate which method releases more l-asparaginase from the cells. The enzyme was extracted by the freeze-grinding method as described previously, with frozen cells ground in a pre-chilled mortar and pestle in an ice bath until a powder was obtained. The macerated biomass was suspended in Tris-HCl buffer, homogenized on a vortex, and centrifuged and the supernatant was used as a crude enzyme extract. For sonication, thawed cells were suspended (0.5 g mL−1) in 50 mM Tris-HCl buffer pH 8.6 and sonicated in a Model 120 Sonic Dismembrator (model FB-120, Thermo Fisher Scientific). The distance between the bottom of the 50 mL centrifuge tube where the sample was stored and the sonicator tip end was maintained at approximately 1 cm throughout the process. Sonication was performed at 120 W, 20 kHz and 40% amplitude in an ice bath. The cells were sonicated for 8 cycles of 59 s pulse on and then allowed to cool down for 30 s pulse off [53]. The homogenate was centrifuged at 3100× g for 15 min at 4 °C and the supernatant was used as crude enzyme extract.
2.12. Scanning Electron Microscopy Analysis
Morphological changes of Penicillium sp. 2DSST1 subjected to mechanical methods for fungal cell disruption were evaluated under scanning electron microscopy (SEM). Biomass that had previously been macerated, sonicated and untreated, used as a control, were prepared as liquid cultured microorganisms [54]. Cells (100 mg) were resuspended in a fixative buffer (0.1 M sodium cacodylate with 5% (w/v) glutaraldehyde, pH 7.2), followed by resuspension in sodium cacodylate buffer without glutaraldehyde. Samples were washed with autoclaved water, dehydrated through increased ethanol concentrations (35, 50, 75, 95 and 100%) and air dried with hexamethyldisilazane for 15 min twice [55]. Samples were mounted onto a SEM sample stub with a carbon adhesive tape, sputter coated with 4 nm platinum using a Quorum Technologies Q150T sputter coater (Quorum Technologies Ltd., Lewis, UK) and imaged with a Zeiss SIGMA field emission gun scanning electron microscope (FEG-SEM, Carl Zeiss AG, Jena, Germany) using a Zeiss Everhart-Thornley secondary electron detector with electron high tension at 5.00 kV, signal A SE2, and working distance of 8.5 mm.
3. Results
Thirty-nine fungal isolates from the Brazilian Savanna were evaluated for l-asparaginase production, out of which 21 were isolated from the soil and 18 from plants.
3.1. Primary Screening Using the Semi-Quantitative Method
l-asparaginase production is accompanied by an increase in the pH of the culture filtrates due to the breakdown of l-asparagine releasing aspartic acid and ammonia, which alkalinizes the medium. The plate assay utilizes this principle by incorporating the pH indicator phenol red in a medium containing l-asparagine, which turns pink at alkaline pH; thus, a pink zone is formed around microbial colonies producing l-asparaginase (Figure 1) [33].
Figure 1.
Semi-quantitative screening of the l-asparaginase production of fungi isolated from the Brazilian Savanna in a solid medium supplemented with phenol red containing a single source of nitrogen (l-asparagine or sodium nitrate). The presence of a red halo on the plates represents the potential of high l-asparaginase production. l-asparagine as enzyme substrate (left) and sodium nitrate as control (right): (a) 2DCSS6; (b) 2DSST1; (c) DCFS10.
Out of the 39 isolates from the Brazilian Savanna soil and plants, 27 showed growth on l-asparagine media after 48 h of incubation, of which 14 (14/27) isolates showed a zone diameter twice the colony diameter (index > 2): two Aspergillus isolates (DCFS1 and 2DCSS6), eight Penicillium isolates (DCFS6, RCFS24, 2DSST1, 2DMGSE2, RCFS6, 2DSST10, RCFT14 and DCFF2), one Fusarium isolate (DCFS10) and three unidentified endophytes (CAG2, EP03 and EP01). Twelve isolates (12/39) did not grow on l-asparagine media, out of which 10 isolates were endophytes (BR, CAG, CAG1, CAG3, CAM01, CB02, GOI03, IPE02, OH01, OH03, Aspergillus sp. DCFS9 and Fusarium sp. RCFS3). Results are given as zone index values, calculated as the ratio of the zone diameter to the colony diameter, as shown in Table 3.
Table 3.
Zone index values for the isolates obtained from Brazilian Savanna samples using phenol red as indicator representing their extent of crude l-asparaginase production after 48 h of incubation.
The isolates of fungi from the Brazilian Savanna showed higher or similar zone indexes in a shorter incubation period compared to the data found in the literature. The maximum value of the zone index for Trichosporon asahii IBBLA1 isolated from Antarctica was 5.8 after 96 h of incubation [27]. Curvularia sp. S3.4, Rhizopus sp. W3, Rhizopus sp. W5, Aspergillus sp. C3, Aspergillus sp. C7 and Aspergillus sp. MTCC 1782 isolated from the soils of India produced zone indices ranging from 1.0 to 2.40 and 1.18 to 2.40 using phenol red and bromothymol blue indicators, respectively, after 72 h of incubation [18]. Penicillium sp. T6.2, Penicillium sp. T8.3, and Fusarium sp. T22.2 produced a zone index greater than 1.0 after 72 h in cultures inoculated with conidia; Penicillium sp. T9.1 also produced a zone index greater than 1.0, but after 168 h, while Penicillium sp. T6.1 reached zone index 0.88 after 168 h using bromothymol blue dye [56].
3.2. Confirmatory Screening Using Quantitative Method
The quantitative assay for the determination of l-asparaginase-producing fungi was performed after submerged fermentation of each isolate. l-asparaginase activity was measured in the cells from the amount of aspartate hydroxamate produced from asparagine and hydroxylamine (Figure 2), a method considered the most sensitive when compared to ammonia quantitation produced from asparagine using Nessler’s reagent, although giving similar results [57]. However, current estimates of l-asparaginase activity reported in the literature may be overestimated when Nessler reagent is used. The Nessler method is an indirect measurement of asparaginase activity that determines the concentration of ammonia; however, ammonia is also generated throughout microbial fermentations, which will also reduce the Nessler reagent if crude microbial extracts are used to determine the total l-asparaginase activity. Therefore, this interference does not allow a reliable comparison of results [58].
Figure 2.
Distribution of l-asparaginase activity quantified in the cells of 39 fungal isolates from the Brazilian Savanna grown under submerged fermentation. Results are presented as mean ± standard deviation of enzyme activity. Brown bar: soil isolates; green bar: endophytes.
The l-asparaginase activity values ranged from 0 to 2.29 U g−1. The highest values of l-asparaginase activity (>0.5 U g−1) were obtained by filamentous fungi isolated from the soil (isolates DCFS6, DCFS10, RCFT14, DCFS1, 2DCSS6 and 2DSST1), whereas all endophytes produced the lowest values of enzymatic activity (<0.5 U g−1). The isolates that presented the highest l-asparaginase activity values obtained by quantitative screening after submerged fermentation corroborated with the high zone indices obtained by semi-quantitative screening in solid media and were screened for glutaminase activity.
3.3. Glutaminase Screening Using the Quantitative Method
There was no significant difference between the l-asparaginase and glutaminase activity levels by Penicillium sp. RCFT14 (p = 0.0821) and Aspergillus sp. DCFS1 (p = 0.3429), the latter having glutaminase activity higher than l-asparaginase activity (Figure 3). On the other hand, the values of l-asparaginase activity from isolates Fusarium sp. DCFS10 (p = 0.0022), Penicillium sp. 2DSST1 (p = 0.0224) and DCFS6 (p = 0.0056) were significantly higher than its glutaminase activity; therefore, Fusarium sp. DCFS10 and Penicillium sp. 2DSST1 were selected for further experiments due to the highest values of l-asparaginase activity with the lowest values of glutaminase activity.
Figure 3.
Distribution of enzyme activity quantified in the cells of fungal isolates from the Brazilian Savanna soil grown under submerged fermentation. Results are presented as mean ± standard deviation of enzyme activity. Red bar: l-asparaginase; purple bar: glutaminase.
3.4. Identification of the Most Promising Cultures
Upon analysis with the sequences in Genbank and phylogenetic clustering analysis, it was established that the sequences of fungal strains showed a high percentage of identity with tub2, ef-1α, and its sequences from Fusarium and tub2, cam, its and rpb2 sequences from Penicillium. The accession numbers in GenBank were MT790711 (its), MT815922 (cam), MT815923 (tub2) and MT815924 (rpb2) for Penicillium and MT790712 (its), MT815925 (tub2) and MT815926 (ef-1α) for Fusarium. The same sequences were used in the multigenic identification of species. Based on the multilocus analysis, the isolates Penicillium sp. 2DSST1 and Fusarium sp. DCFS10 were identified as Penicillium sizovae (Figure 4a) and Fusarium proliferatum (Figure 4b), respectively.
Figure 4.
Bayesian phylogenetic tree based on concatenate sequences: (a) its, cam, tub2, rpb2 of Penicillium species section Citrina; (b) tub2 and ef-1α of the Fusarium fujikuroi species complex. Bayesian posterior probabilities are indicated at the nodes, and the scale bar represents the number of expected changes per site. Ex-type isolates are indicated with an asterisk (*), and the isolates reported here are highlighted in bold.
3.5. Screening of Variables for l-Asparaginase Production by Plackett–Burman Design
The first step in process optimization is the screening of important variables, followed by the estimation of optimal levels of these variables [59]. PBD was employed as an efficient screening method to identify the variables that most influence the production of l-asparaginase using as few experimental runs as possible (Table 2). The values of l-asparaginase activities of the isolated P. sizovae according to PBD varied between 0 and 3.68 ± 0.14 U mL−1. The highest value of l-asparaginase activity was obtained in run number 7, in a culture medium composed of 1% (w/v) l-proline, 3% (w/v) l-asparagine, 3% (w/v) sodium nitrate, 3% (w/v) ammonium sulfate, 3% (w/v) peptone, 3% (w/v) yeast extract, incubated at 32 °C and added with one mycelial disc. The carbon:nitrogen (C:N) ratio of 1.53, the second lowest of all culture media on PBD, shows that the P. sizovae strain requires less carbon available in the culture medium to obtain the highest yield of l-asparaginase. The balance of nutrients in a culture medium, especially the C:N ratio, can influence the growth and sporulation of the fungus [60]. It was possible to observe a reduction in the production of fungal biomass in the culture media with the lowest C:N ratios. There was little to no growth of biomass in the culture medium with the lowest C:N ratio, represented by run number 5 according to PBD; therefore, no enzymatic activities were recorded on this run.
The values of l-asparaginase activity of the isolated F. proliferatum according to PBD varied between 0.04 ± 0.01 U mL−1 and 1.86 ± 0.12 U mL−1. The highest values of l-asparaginase activity and specific enzyme activity were obtained in run number 13, in a culture medium composed of 1% (w/v) l-proline, 3% (w/v) l-asparagine, 3% (w/v) ammonium sulfate, 3% (w/v) peptone, 1% (w/v) glucose, 3% (w/v) malt extract, incubated at 32 °C and added with five mycelial discs. The 2.46 C:N ratio shows that the fungus needs approximately two and a half times more carbon than nitrogen in the composition of the culture medium to obtain the highest yield of l-asparaginase.
The results calculated by Protimiza Experimental Design software (Table 4) for l-asparaginase activities (U mL−1) and specific enzyme activities (U mg−1) obtained by P. sizovae show that peptone, yeast extract, urea, l-proline, ammonium sulfate, temperature and l-asparagine are the variables with positive effects on the production of l-asparaginase, that is, they represent an increase in l-asparaginase activities due to an increase in the concentration of variables, while inoculum, sucrose and glucose had negative effects, that is, they represent a decrease in l-asparaginase activities due to an increase in the concentration of variables. Malt extract had a negative effect on the l-asparaginase activity and a positive effect on the specific enzyme activity, that is, the higher the concentration of malt extract, the lower the enzymatic activity and the greater the specific enzyme activity, as it has fewer interfering proteins. Sodium nitrate had a positive effect on the activity of l-asparaginase and a negative effect on the specific enzyme activity, that is, the higher the concentration of sodium nitrate, the greater the enzymatic activity and the lower the specific activity due to the presence of more proteins in the culture medium, probably the increased production of nitrate reductase to hydrolyze the substrate sodium nitrate [61].
Table 4.
Effects and significance of variables for l-asparaginase activity and specific enzyme activity by P. sizovae and F. proliferatum from the results of Plackett–Burman experimental design.
The p value is used as a tool to check the significance of each of the coefficients, which in turn may indicate the pattern of the interactions between the variables [34]. Peptone, yeast extract, inoculum size, sucrose, glucose, urea, and l-proline are significant variables of the model, while sodium nitrate, l-asparagine and malt extract are not significant variables of the model for both l-asparaginase activity and specific enzyme activity by P. sizovae. Ammonium sulfate is significant for l-asparaginase activity but not for specific enzyme activity, while temperature is not significant for l-asparaginase activity but for specific enzyme activity. The highest values of l-asparaginase activity and specific enzyme activity by PBD were obtained by cultivating P. sizovae at the lowest level of inoculum in the absence of glucose and sucrose, corroborating the results of significant and negative effects of these variables. For some microorganisms, glucose proved to be a poor carbon source for the production of l-asparaginase, which can also decrease the enzyme’s performance, acting as a repressor when used in greater concentrations [62,63,64,65]. This may be due to catabolic repression caused by glucose and catabolic inhibition of the components involved in lactate transport and by lactate-stimulated l-asparaginase synthesis [66].
Malt extract, temperature, peptone, glucose, inoculum size and l-asparagine are the variables that showed positive effects on the production of l-asparaginase by F. proliferatum, whereas ammonium sulfate, sucrose, urea, sodium nitrate and proline showed negative effects. Malt extract was the only significant variable of the model for both l-asparaginase activity and specific enzyme activity. Higher concentrations of carbon sources, such as malt extract and glucose, increased l-asparaginase production by F. proliferatum, different from that observed by P. sizovae.
3.6. Kinetic Parameters of Cellular Growth
The lag phase was observed between 0 and 24 h with cell growth lower than 1 g/L and maximum cell growth was observed after 96 h of cultivation for both P. sizovae (Figure 5a) and F. proliferatum (Figure 5b). Penicillium sizovae l-asparaginase was undetectable at 24 h. Maximum l-asparaginase specific activity was observed after 48 h and 72 h of cultivation for P. sizovae and F. proliferatum, respectively, during the exponential phase, showing that l-asparaginase production is of fungal primary metabolism.
Figure 5.
Variation of biomass (■) after 120 h and l-asparaginase specific activity (♦) after 96 h of incubation at 32 °C and 120 rpm: (a) P. sizovae; (b) F. proliferatum. Results are presented as mean ± standard deviation.
The kinetic parameters of fungal growth and l-asparaginase production were compared when the isolates were cultivated in MCDM before the screening of variables (bPBD) and in the culture medium in which the highest l-asparaginase activity was obtained by PBD (aPBD). The maximum biomass productivity of both isolates was reduced after the screening of culture media variables, which is justified by the reduction of carbon sources in the culture medium, thus reducing fungal biomass. The maximum enzyme productivity was increased 3-fold by F. proliferatum and 4-fold by P. sizovae after PBD. Specific enzyme yield was increased 4-fold by F. proliferatum and 3-fold by P. sizovae after the screening of culture media variables. The biomass conversion factor in the enzyme by F. proliferatum was increased 4-fold, while by P. sizovae it increased 7-fold (Table 5).
Table 5.
Kinetic parameters of growth and l-asparaginase production by P. sizovae and F. proliferatum.
3.7. Fungal Cell Disruption Mechanical Methods for l-Asparaginase Release
Freezing and grinding the fungal biomass was the most efficient method for l-asparaginase release from P. sizovae. l-asparaginase activity and specific enzyme activity from P. sizovae extracted by the freeze-grinding method (2.35 ± 0.03 U mL−1, 0.80 U mg−1) were 5-fold and 2-fold, respectively, greater than the values obtained from the sonication method (0.48 ± 0.02 U mL−1, 0.36 U mg−1), suggesting that the freeze-grinding method promoted fungal cell disruption, thus releasing more l-asparaginase when compared to the sonication method (Figure 6). The highest yield of protein extraction from fungal cell was achieved by mechanical treatment, which was revealed to be the most effective for the disintegration of filamentous fungi cells, specifically A. fumigatus and P. citrinum, the latter belonging to the same phylogenetic section of P. sizovae. Additionally, the freezing and grinding method was the simplest and fastest method used for l-asparaginase release [53].
Figure 6.
SEM photographs of Penicillium sizovae. (A,B) Hyphal cells and chlamydospore (white arrow) formed in a liquid medium; (C,D) disruption of hyphae (white arrow) subjected to mechanical extraction by maceration with mortar and pestle; (E,F) disruption of hyphae (white arrows) and a greater number of holes in the mycelium submitted to physical maceration by sonication. Bars (A–F) = 2 µm.
3.8. Scanning Electron Microscopy Analysis
Changes in the mycelium of P. sizovae subjected to mechanical methods for fungal cell disruption were observed under SEM and compared with a control sample. It was possible to visualize the terminal chlamydospores formed in the hyphae of the intact biomass used as control (Figure 6A,B). Disrupted hyphae with release of the chlamydospores were visualized in the macerated sample (Figure 6C,D), similar to SEM images of P. expansum spores that had been crushed and that exhibited a high degree of hollowness on the spore surface [55]. Disruption of hyphae and a greater number of holes in mycelium were visualized in the sample submitted to physical maceration by sonication (Figure 6E,F). This indicates that disruption is more efficient than the formation of holes in hyphae to release the cellular content. Therefore, it is possible to infer that the maceration method seems to have a deeper damaging effect on fungal cells compared to sonication.
4. Conclusions
This study evaluated the biotechnological potential of filamentous fungal isolates from different samples of Brazilian Savanna for the production of l-asparaginase of industrial and pharmaceutical interest. Twenty-one fungal strains obtained from the soil and 18 fungal strains obtained from the leaves of plants from the Brazilian Savanna were screened for enzyme production, out of which two fungi, P. sizovae and F. proliferatum, obtained from the soil were selected as the greatest l-asparaginase producers with the lowest glutaminase activity. The Plackett–Burman design was used to evaluate the culture medium variables that influence l-asparaginase activity and specific enzyme activity. The highest values of total enzymatic activity were recorded at 3.68 ± 0.14 U mL−1 and 1.86 ± 0.12 U mL−1 for P. sizovae and F. proliferatum, respectively. Carbon sources such as glucose, sucrose and malt extract were found to be a repressor of enzyme synthesis by P. sizovae. On the other hand, l-asparaginase production by F. proliferatum was enhanced with higher levels of carbon sources such as glucose and malt extract and inoculum size. The Plackett–Burman design improved the enzyme productivity, specific enzyme yield and biomass conversion factor in the enzyme of the isolates. Freeze-grinding was proved to be the best mechanical method for the disruption of fungal cells for l-asparaginase release, as it was seen that it promoted the extravasation of cellular content of P. sizovae compared to sonicated and control samples. This study shows the upstream processing of l-asparaginase production by fungal species isolated from the Brazilian Savanna soil with low glutaminase activity. The evaluation of nutrient and culture conditions as well as the evaluation of efficient fungal cell disruption methods enhanced the l-asparaginase yield, thus being the most efficient and optimized methods employed in upstream processing for l-asparaginase production by the selected isolates. The discovery of novel l-asparaginase producers such as P. sizoave and F. proliferatum of eukaryotic origin with low glutaminase activity isolated from a global biodiversity hotspot may lead to safer alternatives for patients who develop treatment-limiting side effects due to their potential to be less immunogenic and thus is an improvement in ALL therapy worldwide.
Author Contributions
Conceptualization, A.P. and P.O.M.; methodology, M.F., A.P. and P.O.M.; software, M.F., J.I. and P.O.M.; formal analysis, M.F., P.S., S.C., K.C., L.S.A. and D.B.P.; investigation, M.F.; resources, E.X.F.F., J.I., A.P. and P.O.M.; data curation, M.F., P.S., K.C. and D.B.P.; writing—original draft preparation, M.F.; writing—review and editing, P.S., K.C., J.I., D.B.P. and P.O.M.; visualization, M.F.; supervision, P.O.M.; project administration, A.P. and P.O.M.; funding acquisition, P.O.M. All authors have read and agreed to the published version of the manuscript.
Funding
This study was financed in part by the Higher Education Personnel Improvement Coordination (Capes)—Finance Code 001 and the Federal District Research Support Foundation (FAP-DF)—process numbers 193.001.661/2017 and 193.0000.919/2020-07.
Institutional Review Board Statement
Not applicable.
Informed Consent Statement
Not applicable.
Data Availability Statement
Not applicable.
Acknowledgments
The authors thank the University of Brasilia (UnB), the University of Brighton (UoB), and Jonathan Salvage from the Image and Analysis Unit at UoB School of Pharmacy and Biomolecular Sciences for microscopic imaging.
Conflicts of Interest
The authors declare no conflict of interest.
References
- WHO. World Health Organization Model List of Essential Medicines, 21st List, 2019; World Health Organization: Geneva, Switzerland, 2019; Licence: CC BY-NC-SA 3.0 IGO; Available online: https://www.who.int/publications/i/item/WHOMVPEMPIAU2019.06 (accessed on 22 November 2020).
- Bahreini, E.; Aghaiypour, K.; Abbasalipourkabir, R.; Goodarzi, M.T.; Saidijam, M.; Safavieh, S.S. An optimized protocol for overproduction of recombinant protein expression in Escherichia coli. Prep. Biochem. Biotechnol. 2014, 44, 510–528. [Google Scholar] [CrossRef] [PubMed]
- Goodsell, D.S. The molecular perspective: l-asparaginase. Oncologist 2005, 10, 238–239. [Google Scholar] [CrossRef] [PubMed][Green Version]
- Cachumba, J.J.M.; Antunes, F.A.F.; Peres, G.F.D.; Brumano, L.P.; Santos, J.C.D.; Da Silva, S.S. Current applications and different approaches for microbial l-asparaginase production. Braz. J. Microbiol. 2016, 47, 77–85. [Google Scholar] [CrossRef] [PubMed]
- Badoei-Dalfard, A. l-asparaginase production in the Pseudomonas pseudoalcaligenes strain JHS-71 isolated from Jooshan Hot-spring. Mol. Biol. Res. Commun. 2016, 5, 1–10. [Google Scholar]
- Broome, J.D. Evidence that the l-asparaginase activity of guinea pig serum is responsible for its antilymphoma effects. Nature 1961, 191, 1114–1115. [Google Scholar] [CrossRef]
- Lopes, A.M.; Oliveira-Nascimento, L.; Ribeiro, A.; Tairum, C.A., Jr.; Breyer, C.A.; Oliveira, M.A.; Monteiro, G.; Souza-Motta, C.M.; Magalhaes, P.O.; Avendano, J.G.; et al. Therapeutic l-asparaginase: Upstream, downstream and beyond. Crit. Rev. Biotechnol. 2015, 37, 82–99. [Google Scholar] [CrossRef]
- Bascomb, S.; Banks, G.T.; Skarstedt, M.T.; Fleming, A.; Bettelheim, K.A. The properties and large-scale production of l-asparaginase from Citrobacter. J. Gen. Microbiol. 1975, 91, 1–16. [Google Scholar] [CrossRef][Green Version]
- Brumano, L.P.; da Silva, F.V.S.; Costa-Silva, T.A.; Apolinário, A.C.; Santos, J.H.P.M.; Kleingesinds, E.K.; Monteiro, G.; Rangel-Yagui, C.d.O.; Benyahia, B.; Junior, A.P. Development of l-Asparaginase Biobetters: Current Research Status and Review of the Desirable Quality Profiles. Front. Bioeng. Biotechnol. 2019, 6, 212. [Google Scholar] [CrossRef]
- Pieters, R.; Hunger, S.P.; Boos, J.; Rizzari, C.; Silverman, L.; Baruchel, A.; Goekbuget, N.; Schrappe, M.; Pui, C.H. l-asparaginase treatment in acute lymphoblastic leukemia: A focus on Erwinia asparaginase. Cancer 2011, 117, 238–249. [Google Scholar] [CrossRef]
- Keating, M.J.; Holmes, R.; Lerner, S.; Ho, D.H. l-asparaginase and PEG asparaginase—Past, present, and future. Leuk. Lymphoma 1993, 10, 153–157. [Google Scholar] [CrossRef]
- Evans, W.E.; Tsiatis, A.; Rivera, G.; Murphy, S.B.; Dahl, G.V.; Denison, M.; Crom, W.R.; Barker, L.F.; Mauer, A.M. Anaphylactoid reactions to Escherichia coli and Erwinia asparaginase in children with leukemia and lymphoma. Cancer 1982, 49, 1378–1383. [Google Scholar] [CrossRef]
- Caruso, V.; Iacoviello, L.; Di Castelnuovo, A.; Storti, S.; Donati, M.B. Venous thrombotic complications in adults undergoing induction treatment for acute lymphoblastic leukemia: Results from a meta-analysis. J. Thromb. Haemost. 2007, 5, 621–623. [Google Scholar] [CrossRef]
- Albertsen, B.K.; Schroder, H.; Jakobsen, P.; Avramis, V.I.; Muller, H.J.; Schmiegelow, K.; Carlsen, N.T. Antibody formation during intravenous and intramuscular therapy with Erwinia asparaginase. Med. Pediatr. Oncol. 2002, 38, 310–316. [Google Scholar] [CrossRef]
- Heitink-Polle, K.M.; Prinsen, B.H.; de Koning, T.J.; van Hasselt, P.M.; Bierings, M.B. High incidence of symptomatic hyperammonemia in children with acute lymphoblastic leukemia receiving pegylated asparaginase. JIMD Rep. 2013, 7, 103–108. [Google Scholar] [CrossRef]
- Fonseca, M.H.G.; Fiúza, T.d.S.; Morais, S.B.d.; Souza, T.d.A.C.B.d.; Trevizani, R. Circumventing the side effects of l-asparaginase. Biomed. Pharm. 2021, 139, 111616. [Google Scholar] [CrossRef]
- Sarquis, M.I.; Oliveira, E.M.; Santos, A.S.; Costa, G.L. Production of l-asparaginase by filamentous fungi. Mem. Inst. Oswaldo Cruz. 2004, 99, 489–492. [Google Scholar] [CrossRef]
- Doriya, K.; Kumar, D.S. Isolation and screening of l-asparaginase free of glutaminase and urease from fungal sp. 3 Biotech 2016, 6, 239. [Google Scholar] [CrossRef]
- Warrell, R.P., Jr.; Chou, T.C.; Gordon, C.; Tan, C.; Roberts, J.; Sternberg, S.S.; Philips, F.S.; Young, C.W. Phase I evaluation of succinylated Acinetobacter glutaminase-asparaginase in adults. Cancer Res. 1980, 40, 4546–4551. [Google Scholar]
- Greenberg, D.M.; Blumenthal, G.; Ramadan, M.E. Effect of administration of the enzyme glutaminase on the growth of cancer cells. Cancer Res. 1964, 24, 957–963. [Google Scholar]
- Avramis, V.I. Asparaginases: Biochemical pharmacology and modes of drug resistance. Anticancer Res. 2012, 32, 2423–2437. [Google Scholar]
- Hendriksen, H.V.; Kornbrust, B.A.; Ostergaard, P.R.; Stringer, M.A. Evaluating the potential for enzymatic acrylamide mitigation in a range of food products using an asparaginase from Aspergillus oryzae. J. Agric. Food Chem. 2009, 57, 4168–4176. [Google Scholar] [CrossRef]
- Xu, F.; Oruna-Concha, M.J.; Elmore, J.S. The use of asparaginase to reduce acrylamide levels in cooked food. Food Chem. 2016, 210, 163–171. [Google Scholar] [CrossRef]
- Myers, N.; Mittermeier, R.A.; Mittermeier, C.G.; da Fonseca, G.A.B.; Kent, J. Biodiversity hotspots for conservation priorities. Nature 2000, 403, 853–858. [Google Scholar] [CrossRef]
- Strassburg, B.B.N.; Brooks, T.; Feltran-Barbieri, R.; Iribarrem, A.; Crouzeilles, R.; Loyola, R.; Latawiec, A.E.; Oliveira Filho, F.J.B.; Scaramuzza, C.A.d.M.; Scarano, F.R.; et al. Moment of truth for the Cerrado hotspot. Nat. Ecol. Evol. 2017, 1, 99. [Google Scholar] [CrossRef]
- Eiten, G. The cerrado vegetation of Brazil. Bot. Rev. 1972, 38, 201–341. [Google Scholar] [CrossRef]
- Ashok, A.; Doriya, K.; Rao, J.V.; Qureshi, A.; Tiwari, A.K.; Kumar, D.S. Microbes producing l-asparaginase free of glutaminase and urease isolated from extreme locations of antarctic soil and moss. Sci. Rep. 2019, 9, 1423. [Google Scholar] [CrossRef]
- Silva, L.F.; Freire, K.T.L.S.; Araújo-Magalhães, G.R.; Agamez-Montalvo, G.S.; Sousa, M.A.; Costa-Silva, T.A.; Paiva, L.M.; Pessoa-Junior, A.; Bezerra, J.D.P.; Souza-Motta, C.M. Penicillium and Talaromyces endophytes from Tillandsia catimbauensis, a bromeliad endemic in the Brazilian tropical dry forest, and their potential for l-asparaginase production. World J. Microbiol. Biotechnol. 2018, 34, 162. [Google Scholar] [CrossRef]
- Pádua, A.P.S.L.d.; Freire, K.T.L.d.S.; Oliveira, T.G.L.d.; Silva, L.F.d.; Araújo-Magalhães, G.R.; Agamez-Montalvo, G.S.; Silva, I.R.d.; Bezerra, J.D.P.; Souza-Motta, C.M.d. Fungal endophyte diversity in the leaves of the medicinal plant Myracrodruon urundeuva in a Brazilian dry tropical forest and their capacity to produce l-asparaginase. Acta Bot. Bras. 2019, 33, 39–49. [Google Scholar] [CrossRef]
- Santos, M.G.S.; Bezerra, J.D.P.; Svedese, V.M. Screening of endophytic fungi from cactus of the Brazilian tropical dry forest according to their l-asparaginase activity. Sydowia Horn. 2015, 67, 147–156. [Google Scholar] [CrossRef]
- Souza, P.M.; de Freitas, M.M.; Cardoso, S.L.; Pessoa, A.; Guerra, E.N.S.; Magalhães, P.O. Optimization and purification of l-asparaginase from fungi: A systematic review. Crit. Rev. Oncol. Hematol. 2017, 120, 194–202. [Google Scholar] [CrossRef] [PubMed]
- Werneck, G.; Pereira, C.B.; Almeida, R.; de Freitas, M.M.; Silveira, D.; Fonseca-Bazzo, Y.; Magalhães, P. Screening of proteases production by endophytic fungi isolated of Brazilian Savanna plants. In Proceedings of the Anais do Simpósio Nacional de Bioprocessos e Simpósio de Hidrólise Enzimática de Biomassas, Fortaleza, Ceará, Brazil, 1–4 September 2015; Galoá: Campinas, Brazil, 2015. Abstract Number 33813. [Google Scholar]
- Gulati, R.; Saxena, R.K.; Gupta, R. A rapid plate assay for screening l-asparaginase producing micro-organisms. Lett. Appl. Microbiol. 1997, 24, 23–26. [Google Scholar] [CrossRef]
- Baskar, G.; Renganathan, S. Optimization of L -asparaginase production by Aspergillus terreus MTCC 1782 using response surface methodology and artificial neural network-linked genetic algorithm. Asia-Pac. J. Chem. Eng. 2012, 7, 212–220. [Google Scholar] [CrossRef]
- Drainas, C.; Kinghorn, J.R.; Pateman, J.A. Aspartic hydroxamate resistance and asparaginase regulation in the fungus Aspergillus nidulans. J. Gen. Microbiol. 1977, 98, 493–501. [Google Scholar] [CrossRef]
- Gardes, M.; Bruns, T.D. ITS primers with enhanced specificity for basidiomycetes--application to the identification of mycorrhizae and rusts. Mol. Ecol. 1993, 2, 113–118. [Google Scholar] [CrossRef]
- White, T.J.; Bruns, T.; Lee, S.; Taylor, J.W. Amplification and direct sequencing of fungal ribosomal RNA genes for phylogenetics. In PCR Protocols: A Guide to Methods and Applications; Innis, M.A., Gelfand, D.H., Sninsky, J.J., White, T.J., Eds.; Academic Press: New York, NY, USA, 1990. [Google Scholar]
- Glass, N.L.; Donaldson, G.C. Development of primer sets designed for use with the PCR to amplify conserved genes from filamentous ascomycetes. Appl. Environ. Microbiol. 1995, 61, 1323–1330. [Google Scholar] [CrossRef]
- Carbone, I.; Kohn, L.M. A method for designing primer sets for speciation studies in filamentous ascomycetes. Mycologia 1999, 91, 553–556. [Google Scholar] [CrossRef]
- Hong, S.B.; Go, S.J.; Shin, H.D.; Frisvad, J.C.; Samson, R.A. Polyphasic taxonomy of Aspergillus fumigatus and related species. Mycologia 2005, 97, 1316–1329. [Google Scholar] [CrossRef]
- Liu, Y.J.; Whelen, S.; Hall, B.D. Phylogenetic relationships among ascomycetes: Evidence from an RNA polymerase II subunit. Mol. Biol. Evol. 2000, 16, 1799–1808. [Google Scholar] [CrossRef]
- Sandoval-Denis, M.; Swart, W.; Crous, P. New Fusarium species from the Kruger National Park, South Africa. MycoKeys 2018, 34, 63–92. [Google Scholar] [CrossRef]
- Nicolli, C.P.; Haidukowski, M.; Susca, A.; Gomes, L.B.; Logrieco, A.; Stea, G.; Del Ponte, E.M.; Moretti, A.; Pfenning, L.H. Fusarium fujikuroi species complex in Brazilian rice: Unveiling increased phylogenetic diversity and toxigenic potential. Int. J. Food Microbiol. 2020, 330, 108667. [Google Scholar] [CrossRef]
- Houbraken, J.; Frisvad, J.C.; Samson, R.A. Taxonomy of Penicillium section Citrina. Stud. Mycol. 2011, 70, 53–138. [Google Scholar] [CrossRef]
- Houbraken, J.; Kocsubé, S.; Visagie, C.M.; Yilmaz, N.; Wang, X.C.; Meijer, M.; Kraak, B.; Hubka, V.; Samson, R.A.; Frisvad, J.C. Classification of Aspergillus, Penicillium, Talaromyces and related genera (Eurotiales): An overview of families, genera, subgenera, sections, series and species. Stud. Mycol. 2020, 95, 5–169. [Google Scholar] [CrossRef]
- Posada, D.; Buckley, T.R. Model selection and model averaging in phylogenetics: Advantages of akaike information criterion and Bayesian approaches over likelihood ratio tests. Syst. Biol. 2004, 53, 793–808. [Google Scholar] [CrossRef]
- Miller, M.A.; Pfeiffer, W.; Schwartz, T. Creating the CIPRES Science Gateway for inference of large phylogenetic trees. In Proceedings of the Gateway Computing Environments Workshop (GCE), New Orleans, LA, USA, 14 November 2010; pp. 1–8. [Google Scholar]
- Ronquist, F.; Huelsenbeck, J.P. MrBayes 3.2.5: Bayesian phylogenetic inference under mixed models. Bioinformatics 2014, 19, 1572–1574. [Google Scholar] [CrossRef]
- Rambaut, A. FigTree. Available online: http://tree.bio.ed.ac.uk/software/figtree/ (accessed on 3 July 2020).
- Rannala, B.; Yang, Z. Probability distribution of molecular evolutionary trees: A new method of phylogenetic inference. J. Mol. Evol. 1996, 43, 304–311. [Google Scholar] [CrossRef]
- El-Refai, H.A.; El-Shafei, M.S.; Mostafa, H.; El-Refai, A.M.H.; El-Beih, F.M.; Awad, G.E.A.; Easa, S.M.; Gomaa, S.K. Statistical optimization of anti-leukemic enzyme l-asparaginase production by Penicillium cyclopium. Curr. Trends Biotechnol. Pharm. 2014, 8, 130–142. [Google Scholar]
- Farag, A.M.; Hassan, S.W.; Beltagy, E.A.; El-Shenawy, M.A. Optimization of production of anti-tumor l-asparaginase by free and immobilized marine Aspergillus terreus. Egypt. J. Aquat. Res. 2015, 41, 295–302. [Google Scholar] [CrossRef]
- Costa-Silva, T.A.; Flores-Santos, J.C.; Freire, R.K.B.; Vitolo, M.; Pessoa-Jr, A. Microbial cell disruption methods for efficient release of enzyme l-asparaginase. Prep. Biochem. Biotechnol. 2018, 48, 707–717. [Google Scholar] [CrossRef]
- Das Murtey, M.; Ramasamy, P. Sample Preparations for Scanning Electron Microscopy—Life Sciences. In Modern Electron Microscopy in Physical and Life Sciences; Janecek, M., Kral, R., Eds.; IntechOpen: Rijeka, Croatia, 2016; Available online: https://www.intechopen.com/books/modern-electron-microscopy-in-physical-and-life-sciences/sample-preparations-for-scanning-electron-microscopy-life-sciences (accessed on 26 June 2019).
- Jeong, R.D.; Shin, E.J.; Chu, E.H.; Park, H.J. Effects of ionizing radiation on postharvest fungal pathogens. Plant. Pathol. J. 2015, 31, 176–180. [Google Scholar] [CrossRef]
- Gonçalves, A.B.; Maia, A.C.F.; Rueda, J.A.; Vanzela, A.P.d.F.C. Fungal production of the anti-leukemic enzyme l-asparaginase: From screening to medium development. Acta Sci. 2016, 38, 387–394. [Google Scholar] [CrossRef]
- Drainas, C.; Pateman, J.A. l-Asparaginase activity in the fungus Aspergillus nidulans. Biochem. Soc. Trans. 1977, 5, 259–261. [Google Scholar] [CrossRef] [PubMed]
- de Freitas, M.M.; Souza, P.M.; Cruvinel, K.; Barros, T.; Santos, S.N.; Long, P.F.; Pessoa, A.; Magalhaes, P.O. Interferences that impact measuring optimal l-asparaginase activity and consequent errors interpreting these data. Appl. Microbiol. Biotechnol. 2019, 103, 5161–5166. [Google Scholar] [CrossRef] [PubMed]
- Imandi, S.B.; Bandaru, V.V.R.; Somalanka, S.R.; Bandaru, S.R.; Garapati, H.R. Application of statistical experimental designs for the optimization of medium constituents for the production of citric acid from pineapple waste. Bioresour. Technol. 2008, 99, 4445–4450. [Google Scholar] [CrossRef] [PubMed]
- Yu, X.; Hallett, S.G.; Sheppard, J.; Watson, A.K. Application of the Plackett-Burman experimental design to evaluate nutritional requirements for the production of Colletotrichum coccodes spores. Appl. Microbiol. Biotechnol. 1997, 47, 301–305. [Google Scholar] [CrossRef]
- Unkles, S.E.; Wang, R.; Wang, Y.; Glass, A.D.; Crawford, N.M.; Kinghorn, J.R. Nitrate reductase activity is required for nitrate uptake into fungal but not plant cells. J. Biol. Chem. 2004, 279, 28182–28186. [Google Scholar] [CrossRef]
- Lincoln, L.; Niyonzima, F.N.; More, S.S. Purification and properties of a fungal l-asparaginase from Trichoderma viride Pers: SF Grey. J. Microbiol. Biotechnol. Food Sci. 2015, 4, 310–316. [Google Scholar]
- Amena, S.; Vishalakshi, N.; Prabhakar, M.; Dayanand, A.; Lingappa, K. Production, purification and characterization of l-asparaginase from Streptomyces gulbargensis. Braz. J. Microbiol. 2010, 41, 173–178. [Google Scholar] [CrossRef]
- Mukherjee, J.; Majumdar, S.; Scheper, T. Studies on nutritional and oxygen requirements for production of l-asparaginase by Enterobacter aerogenes. Appl. Microbiol. Biotechnol. 2000, 53, 180–184. [Google Scholar] [CrossRef]
- Barnes, W.R.; Dorn, G.L.; Vela, G.R. Effect of culture conditions on synthesis of l-asparaginase by Escherichia coli A-1. Appl. Environ. Microbiol. 1977, 33, 257–261. [Google Scholar] [CrossRef]
- Warangkar, S.C.; Khobragade, C.N. Screening, enrichment and media optimization for l-asparaginase production. J. Cell Tissue Res. 2009, 9, 1963–1968. [Google Scholar]
Publisher’s Note: MDPI stays neutral with regard to jurisdictional claims in published maps and institutional affiliations. |
© 2021 by the authors. Licensee MDPI, Basel, Switzerland. This article is an open access article distributed under the terms and conditions of the Creative Commons Attribution (CC BY) license (https://creativecommons.org/licenses/by/4.0/).